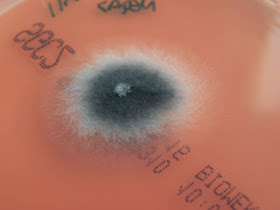
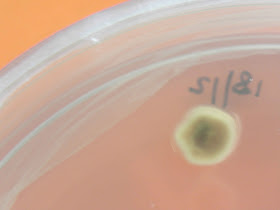

A Curvularia lunata é um fungo filamentoso septado, dematiaceo. É um fungo ubiquitário saprófita do solo
É responsável por queratites e sinusites, pode também ser isolado em lesões cutâneas ou sub-cutâneas.
A colónia apresenta crescimento rápido preenchendo toda a placa em menos de uma semana. A cor é inicialmente verde escura tornando-se com o tempo preto-acinzentado, o reverso é preto. A textura é lanosa.
O exame microscópico revela a presença de conidióforos erectos não ramificados. Os conideos são escuros com três septos, a última célula sendo maior que as restantes e retorcida confere ao conjunto uma forma característica de um ovoide assimétrico com um lado manifestamente curvo e outro lado quase plano. Os conideos apresentam apenas septos transversais e , contrariamente aos da Alternaria, não nascem em cadeias mas sim isoladamente com disposição simpodial.
 |
| Colónia com 2 dias de incubação. |
 |
| Reverso da colónia. |
 |
| Colónia com 7 dias de incubação. |
 |
| Colónia com 12 dias de incubação. |
 |
| Reverso da colónia. |
 |
| Os conidios apresentam apenas septos transversais. Os conideos contrariamente aos da alternária não nascem em cadeias mas sim isoladamente com disposição simpodial. |
 |
| O conidio possui 3 células sendo a célula sub-terminal dilatada de modo assimétrico, sendo muitas vezes mais escura. |